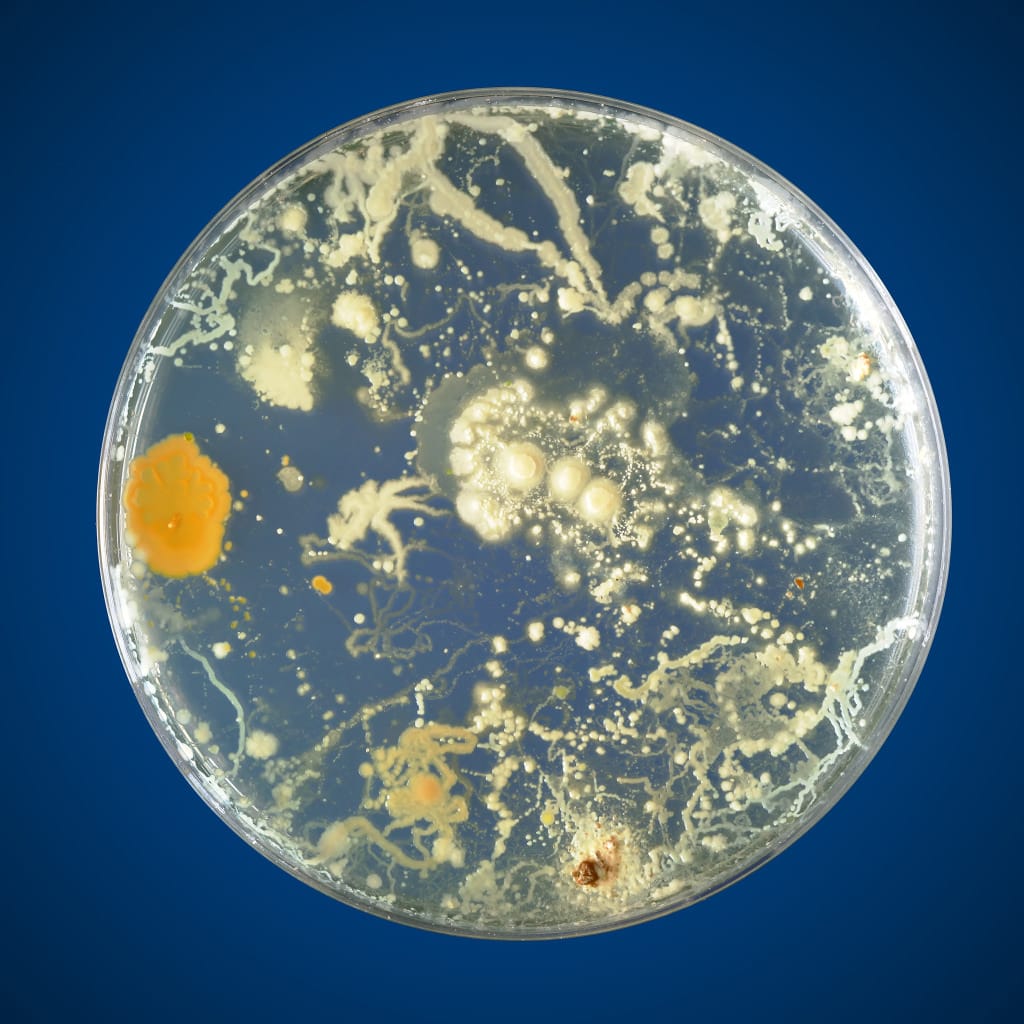

Our respiratory-specific, multi-strain probiotic blend contains Lactiplantibacillus plantarum RSB11®, Lactobacillus acidophilus RSB12®, and Lacticaseibacillus rhamnosus RSB13®, to support lung stru...

Glyphosate-residue free and low FODMAP. This fermentable prebiotic fiber feeds the good bacteria in your gut, like Akkermansia and Bifidobacterium. It repairs the gut lining - improving Leaky Gut a...

B12's nickname could be “energy super booster”. In today's fast-paced environment, we could all use a super boost. B12 supports your nervous system function, energy metabolism, and brain and mood h...

Turmeric (Curcuma longa) root extract
Research finds a wide range of health benefits. Its respiratory uses are well-documented in the Ayurvedic tradition.* More recently, scientists have explored turmeric's immune-supportive and antiox...

Beets are celebrated for their performance-enhancing abilities, driven by their increasing nitric oxide production in the body. Nitric oxide helps positively impact metabolic health, circulation, b...

Holy Basil (Ocimum sanctum) leaf extract
Ocimum sanctum, commonly known as Holy Basil or Tulsi, is also a rockstar of the Ayurvedic tradition, historically used to support a healthy immune system. Scientific inquiry suggests this ancient ...
Why gut health?
Gut-X Axis: The next frontier of microbiome science
For centuries, people have consumed live probiotics as fermented foods for gut health. However, in recent decades, our scientists have discovered that gut microbes also play essential roles in the optimal functioning of other bodily systems. We’ve discovered that our gut is our body's most immunologically active organ, communicating with other organ systems.
The physician-scientists behind res were among the first to sequence targeted restoration. By breaking down the fiber in the gut, we influence the dynamic connections between gut health and targeted bodily functions. This method allows us to deliver targeted benefits through our clinically studied prebiotic and probiotic supplements.
With res, prebiotics, probiotics, and postbiotics aren't just for gut support anymore. We reach far beyond the gut to support multiple Gut-X Axis where the X could stand for the lungs, such as in the Gut-Lung axis, the heart, in the Gut-Heart axis, the brain, in the Gut-Brain axis, and so forth.
What are prebiotics, probiotics, and posbiotics?
Probiotics are live bacteria that benefit our health. When we add probiotics from res supplements and cultured foods, we increase our existing supply of friendly microbes, which help fight off less friendly bacteria.
Prebiotics fuel probiotics, maximizing their hard work in our microbiome.
Postbiotics are nutrient byproducts left behind by probiotics after they consume prebiotics. They help slow down the growth of bad bacteria!
This bacteria community cycle is essential to your whole body health.
¹GLP-1 boost seen in human cellular studies.